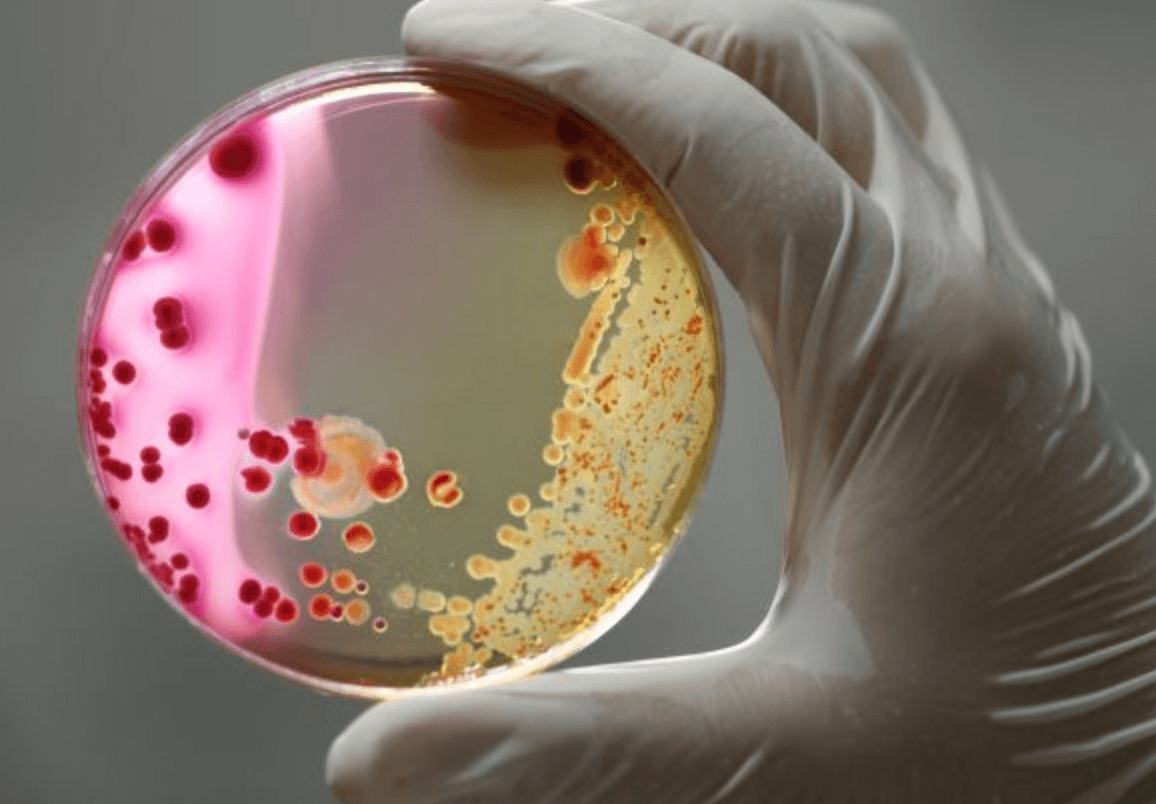

세균성 질염 방치하면 패혈증 원인
- 암 건강
- 2023. 12. 15. 19:04
질염을 방치하고 시간이 지나면 괜찮아 졌다가, 더욱더 심한 질염으로 나타나고, 고열이 발생 했음에도 독감이나 코로나 같은 바이러스로 착각하여 염증이 퍼지는것을 잡지 못해 패혈증과 같은 심각한 합병증이 나타날수 있습니다. 세균성 질염 패혈증 원인에 대한 정보를 공유 합니다.

세균성 질염 원인
질에는 다양한 종류의 박테리아가 서식하고, 유산균이라고 하는 유형은 질의 정상적인 산도를 유지합니다. 이를 통해 유산균은 질 내막을 건강하게 유지하고 감염을 유발하는 특정 박테리아의 성장을 예방하는데 도움이 됩니다.
세균성 질염은 유산균수가 감소하고 일반적으로 존재하는 다른 박테리아의 수가 감소할떄 발생하며, 질염은 박테리아 균형의 변화를 의미합니다. 이러한 세균성 질염을 방치하는 경우 임신중이거나 임신을 시도할때 문제가 발생할수 있습니다.
세균성 질염 증상
세균성 질염의 경우 질 분비물은 황록색 또는 회색이고 묽으며 강한 생선 냄새가 날수 있습니다. 월경기간 동안 냄새가 더 강해질수 있습니다.
- 소변을 볼때 타는듯한 느낌
- 관계후 비린내
- 가려움
- 얇은 흰색, 회색 또는 녹색 분비물
질염 방치하면 패혈증
박테리아는 우리 주변에 존재하는 미세한 단세포 미생물이며, 대부분 무해하며, 오히려 신체가 소화할수 있도록 도와주는 박테리아가 있는 반면 일부 유형의 박테리아는 박테리아 감염을 일으킬수 있습니다. 이는 결국 패혈증을 유발할수 있습니다.
주변에 질염으로 고생을 하다가 괜찮아 진것 같아 방치하다가 고열이 났는데, 독감인줄 알고 병원을 가지 않은 분이 너무 몸이 좋지 않아 병원에가서 검사를 하니 패혈증으로 발전 할번한 경우가 있었습니다.
즉 질염을 별로 크게 중요하게 생각하지 않다가 염증이 퍼지면서 괜찮겠지 방치 한것이 패혈증까지 퍼지는 경우가 종종 있습니다. 아래 패혈증 증상을 참고하시고 혹시나 하는 마음이 있다면 꼭 병원에서 진료를 보셔야 합니다.
패혈증 증상
- 오한
- 빠른 심장박동
- 발열
- 저혈압
- 빠른 호흡
- 피로
- 호흡 곤란
- 현기증
패혈성 쇼크는 혈압이 심하게 떨어지는 것으로 일어서지 못하거나, 졸음이 심하게 오는경우, 극도의 혼란등 정신 상태의 변화가 있다면 패혈성 쇼크로 진행될수 있습니다.

패혈증 원인
모든 염증은 패혈증으로 이어질수 있으며, 박테리아, 바이러스 또는 곰팡이 감염도 포함이 됩니다. 폐렴, 소화 관련 시스템, 혈류, 카테터 사이트, 상처나 화상 및 신장, 방광, 비뇨부분을 통해 패혈증이 발생할수 있습니다.
패혈증이 악화되면 뇌, 심장, 신장과 같은 중요한 기관에 충분한 혈액이 공급되지 않으며, 비정형 혈액 응고를 일으킬수 있습니다. 그로 인하여 작은 혈전이나 혈관이 터지면 조직이 손상되거나 파괴가 됩니다.
경미한 패혈증은 회복될수 있지만, 패혈성 쇼크로 인한 사망율은 30~40%가량이며, 심각한 패혈증이 발생하면 향후 감염 위험이 높아집니다. 이처럼 세균성 질염을 방치하면 패혈증 원인이 될수 있으므로 너무 가렵거나 열이나고 하면 꼭 병원에서 치료를 하세요.
전립선염 증상 원인 치료 방법
최근 전립선염으로 고생하는 남성들의 숫자가 늘어나고 있습니다. 이러한 전립선의 역할은 정자가 여성의 난자로 이동할때 정자를 보호해주는 액체를 만드는 것입니다. 아래 전립선염 증상과
bluelsm.com
VRE균 증상 전염경로 감염
슈퍼박테리아 이런이야기를 들어봤을겁니다 VRE균, CRE균등이 있는데요 오늘은 VRE균에 대해서 그 증상과 어떤 경로로 전염이 이루어지는지 그에 대하여 이야기를 진행할가 합니다. VRE환자는 갈
bluelsm.com
'암 건강' 카테고리의 다른 글
| 귀뒤 멍울 통증 원인 임파선 병원 가세요 (0) | 2024.01.13 |
|---|---|
| 대상포진 수두 걸리는 이유 증상 합병증 (0) | 2024.01.10 |
| 공복혈당 136, 124 당화혈색소 5.8 검사 (0) | 2024.01.01 |
| 메가젠 임플란트 가격 사용 후기 (0) | 2023.12.26 |
| 위내시경 담즙 역류 원인 증상 후기 (0) | 2023.12.12 |
| 발목 인대 끊어짐 병원 수술 비용 보험 청구 (2) | 2023.11.28 |
| 대상포진 예방접종 가격 비용 병원 총정리 (0) | 2023.11.26 |
| 겨드랑이 다한증 수술 치료 방법 (0) | 2023.11.25 |
이 글을 공유하기






